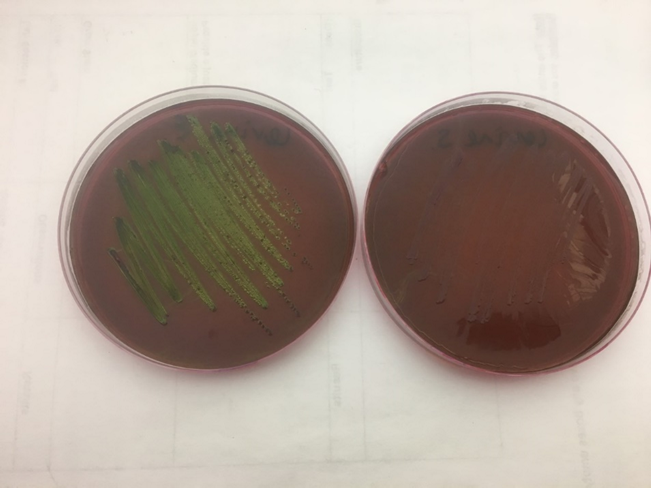
<p>is the right or left positive for Salmonella sp.?</p>
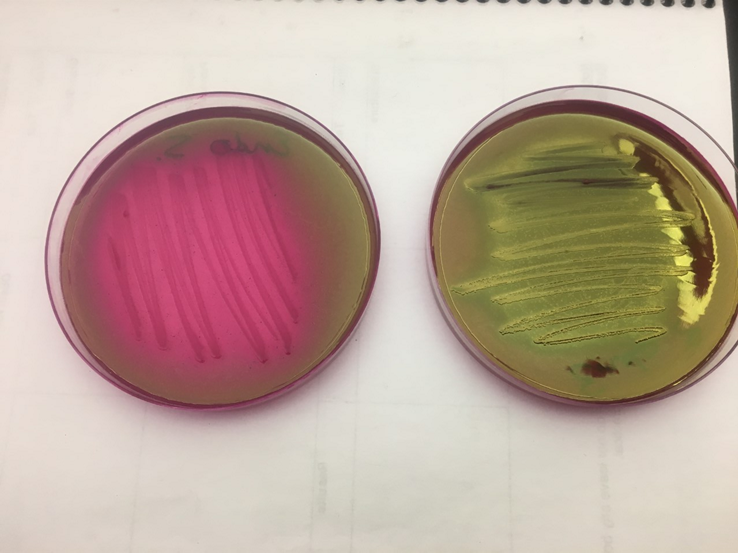
<p>is the right or left positive for E.coli?</p>

Lab 15: Fecal Coliform Determination in Surface Water
1/19
There's no tags or description
Looks like no tags are added yet.
Name | Mastery | Learn | Test | Matching | Spaced |
|---|
No study sessions yet.
20 Terms
define coliform and give an example
can ferment lactose, Escherichia coli
define non-coliform and give an example
cannot ferment lactose, Salmonella
what specific sugar is in the media used for the presumptive test?
lactose
if you have any gas bubbles that were trapped in your lactose broths, what does this indicate? what specific gas are the bacteria producing?
bacteria is capable of fermenting lactose, CO2
what is the name of the inverted test tube found in the DSLB & SSLB test tubes?
Durham test tube
why is E.coli a good sewage indicator? be sure to include three reasons
is not found in soil
easy to grow in laboratory conditions
survives a short time out of the body

what is the selective for EMB?
eosin prevents gram positive

what is the differential for EMB?
blue/black colonies with green sheen
other coliforms = pink colonies
non-coliforms = colorless

is the right or left positive for E.coli?
left

what is selective for Endo?
fuschin inhibits gram positive

what is the differential for Endo?
dark red colonies sometimes with green sheen
non-coliforms = colorless
is the right or left positive for Salmonella sp.?
right
is the right or left positive for E.coli?
right

is the right or left positive for Salmonella sp.
left
what is the purpose of the Durham test tubes?
to collect CO2
presumptive test
designed to screen large numbers of samples quickly
confirmed test
designed to test for the presence of gram negative bacteria
inoculate 10ml, use 10ml pipette
fill to the 0
inoculate 1 ml, use 1 ml pipette
fill to the 0
inoculate 0.1 ml, use 1 ml pipette
fill to the 0.9